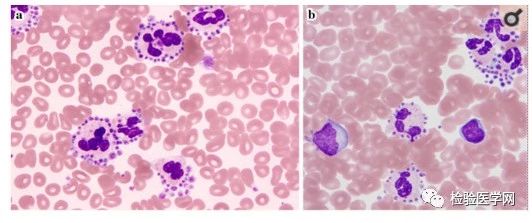

识别应对各种各样的假性血小板减少,这一篇文章就足够了!
作者:何兵冰1,黄华艺1,2
1、深圳迈瑞生物医疗电子股份有限公司体外诊断事业部
2、美国罗斯威尔帕克综合癌症中心肿瘤外科
血小板由骨髓造血组织中的成熟巨核细胞产生,体积小且具有维持血管内皮完整性以及粘附、聚集、释放、促凝和血块收缩等功能。血小板计数作为血细胞常规检测项目之一,其结果直接影响着临床对相关疾病的判断和诊疗计划。日常临床检验工作中可遇到因各种原因引起的体外(试管内)血小板聚集(in vitro platelet agglutination)而导致的假性血小板减少(pseudothrombocytopenia)的现象,若诊断不当,会给患者的治疗过程带来风险,如误诊和误治(图1)。

图1:显微镜下所见的体外血小板聚集
假性血小板减少在所有人群中的发生率约为1‰,而在住院病人中的发生率约为4‰[1]。
血小板聚集可由体内和体外两个方面的因素导致(图2)。

图2:血小板聚集所致的假性血小板减少症的原因
最常见的因体外血小板聚集而引起的假性血小板减少症是由乙二胺四乙酸钠盐(Ethylenediaminetetraacetic acid, EDTA)引起。EDTA依赖的体外血小板聚集而引起的假性血小板减少症(EDTA-PTCP)最早可发生在抽血后的10分钟,血小板计数随之下降,国内学者对EDTA-PTCP的时间进程进行了观察[1](表1、图3)。

表1:EDTA-PTCP的时间与严重性的关系

图3:EDTA-PTCP的时间与严重性的关系
除了图1中显示的显微镜下血小板聚集的形态外,血小板卫星现象也是EDTA导致的一个原因(图4)[2]。
图4:血小板卫星现象
此外,低温导致的冷凝集中可出现红细胞、白细胞和血小板同时聚集的现象。一种遗传性疾病Hegglin综合征可出现巨大血小板现象(图5)。

图5:巨大血小板
因细小凝块而引起的一种血小板聚集情况的原因目前仍未明了。国内学者观察了一组355例体外血小板凝集造成的假性血小板减少的情况并做了详细分析[3]。原始资料引用如下(表2、3):

表2:106例体外血小板聚集造成假性血小板减少症情况分析
根据该报道的资料,106例假性血小板减少的病例中,由EDTA引起的有52例,占49.1%,由EDTA和枸橼酸钠或肝素共同引起的有10例,占9.4%,由三种抗凝剂同时引起的有7例,占6.6%,而因难抽血引起的有28例,占26.4%。可见,EDTA是引起体外聚集而导致假性血小板减少的主要原因。
进一步按临床特征等进行分层分析表明,性别、年龄、疾病类型和季节等与血小板聚集有关(表3)。

表3:性别、年龄、疾病类型和季节等因素与体外血小板聚集有关
由EDTA等引起的体外血小板聚集导致的假性血小板减少(EDTA-PTCP)的病理机制目前仍未完全明了。1969年Gowland[4]等人最先报道了EDTA-PTCP。其发生率各实验室的报道有些出入,从0.07%-0.2%不等,可能与观察的病例情况、人口特征甚至地区性有关[4,5]。关于EDTA-PTCP的发生机制,一般认为患者血液中存在抗血小板自身抗体,在EDTA存在下,自身抗体识别细胞粘附受体糖蛋白IIb-IIIa (GpIIb-IIIa),进一步刺激血小板激活抗原如CD62P (P-selectin,P-选择素)、CD63和thrombospondin(凝血栓蛋白)的表达,促发酪氨酸激酶的激活、血小板聚集,最终导致假性血小板数量的结果[5-7]。图6示EDTA依赖的体外血小板聚集发生机制。

图6:EDTA依赖的体外血小板聚集发生机制
然而,亦有研究提到抗血小板特异性抗体导致的EDTA相关的血小板减少和GPIIb/IIIa位点无关。
✔患者缺乏血小板减少的临床表现
✔血细胞分析仪提示血小板聚集情况的报警
✔血细胞涂片在显微镜下可见血小板聚集现象
✔将样本加热至37℃时可减少血小板聚集
✔用其它抗凝剂重抽血后可减少血小板聚集程度
✔把样本置于37℃保温
✔在EDTA-K2抗凝剂中加入5mg/L的阿米卡星阻断血小板聚集通路
✔在EDTA-K2抗凝剂中加入6g/L的氟化钠进行抗血小板聚集
✔在EDTA-K2抗凝剂中加入噻氯匹定进行抗血小板聚集
✔使用柠檬酸钠或肝素抗凝的采血管重新抽血
✔让病人到实验室机器旁即抽血即上机检测(图7)
然而,上述解决办法的效果并不理想,尤其是再次采血、患者到实验室采血检测,患者、护士和检验科医生都不满意,增加了不必要的劳动量和负担。

图7:患者到实验室机器旁进行即抽血即检验
近年来,国内体外诊断企业研制成功了自动化血细胞分析仪解决EDTA-PTCP的方法,这种方法是血细胞分析仪上的一种叫SF-Cube技术在识别假性血小板减少后能自动打散聚集的血小板,经重新计数后得出准确的血小板数量。图8是国产血细胞分析仪的SF-Cube工作原理简图(解锁干扰新科技)。

图8:迈瑞BC-6000系列血细胞分析仪的SF-Cube技术简图
在检验科的血液学实验室,通常处理EDTA-PTCP的流程如图9。

图9:血液室常规处理EDTA-PTCP的流程图
然而,再次抽血会导致患者不满甚至投诉,进而导致医患关系紧张(图10)。

图10:重抽血会导致患者不满甚至投诉的发生
使用自动化血液分析仪对聚集的血小板进行自动解聚是一种智能化的解决方案,其更易被检验医师、护士和患者接受(图11)。

图11:血液室使用SF-Cube处理EDTA-PTCP的流程图
综上所述,很多因素尤其是EDTA抗凝剂可引起体外血小板聚集而导致假性血小板减少,最终可导致不当的医疗管理行为,造成风险。正确处理这种情况对临床诊疗工作有很大的帮助作用。
【参考文献】
↑↓滑动查看 [1] Lin J, Luo Y, Yao S, Yan M, Li J, OuyangW, Kuang M. Discovery and Correction of Spurious Low Platelet Counts dueto EDTA-Dependent Pseudothrombocytopenia. J Clin Lab Anal 2015;29:419-26. [2] Toishigawa K, Nakagawa H, Furuta T,Fukushima N. Platelet Satellitism. Intern Med 2018;57:1949. [3] Zhang L, Xu J, Gao L, Pan S. SpuriousThrombocytopenia in Automated Platelet Count. Lab Med 2018;49:130-3. [4] Gowland E, Kay HE, Spillman JC, WilliamsonJR. Agglutination of platelets by a serum factor in the presence of EDTA. JClin Pathol 1969;22:460-4. [5] Lippi G, Plebani M. EDTA-dependentpseudothrombocytopenia: further insights and recommendations for prevention ofa clinically threatening artifact. Clin Chem Lab Med 2012;50:1281–5. [6] Isik A, Balcik OS, Akdeniz D, Cipil H, UysalS, Kosar A. Relationship between some clinical situations, autoantibodies, andpseudothrombocytopenia. Clin Appl Thromb Hemost 2012;18:645–9. [7] Dabadie M, Valli N, Jacobin MJ,Laroche-Traineau J, Barat JL, Ducassou D, Nurden AT, Clofent-Sanchez G.Characterisation, cloning and sequencing of a conformation-dependent monoclonalantibody to the alphaIIbbeta3 integrin: interest for use in thrombus detection.Platelets 2001;12:395-405.
致谢:本文得到四川大学华西医院实验医学科应斌武教授和江虹教授,北京协和医院检验科张时民教授,北京解放军总医院医学检验中心李绵洋教授,中山大学附属第一医院检验科刘敏教授提出的修改意见。在此一并感谢!
编辑:Nicole 审校:Rose
来源:检验医学网

